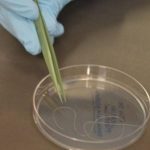

Na manhã desta terça-feira (23), aconteceu no Auditório do SESI, em Santo Antônio da Platina, uma homenagem ao Soldado PM Edson Ribeiro e o Soldado PM Edson Sobejeiro, eleitos os “Policiais Militares Destaques do Mês”. Soldados que ingressaram na carreira militar no ano de 2008. O evento presidido pelo Comandante do 2º BPM, Tenente-Coronel José Luiz de Oliveira, contou com a presença dos familiares dos homenageados, amigos de trabalho, comandante do destacamento de Quatiguá Sargento Petterson, Comandante da 4ª Cia Robson Falk, Juiz Federal de Jacarezinho Rogério Cangussu, os vereadores Pastor Eduardo, Chrysthian Coser, Matheus Pizzol, Secretário de Comunicação Waltinho Chiusoli, bem como com a participação vice-prefeito do município de Quatiguá José de Pádua Melo.rn “Parabéns Soldados Ribeiro e Sobejeiro pela dedicação e esforço, vocês são exemplos a serem seguidos! E saibam que nós de Quatiguá, nos sentimos muito felizes em tê-los como integrantes do nosso destacamento, desejo sucesso em suas carreiras profissionais para que momentos alegres e inesquecíveis como este se repitam sempre”, afirmou a vice-prefeito. rnO comandante, Tenente-Coronel José Luiz de Oliveira destacou: “Estes militares se destacaram pelo empenho e de vocação à atividade militar. Parabéns aos soldados Ribeiro e Sobejeiro do Destacamento de Quatiguá, vocês nos honram com seus trabalhos – esses motivos os tornam dignos de serem homenageados”.rn Fizeram uso da palavra: Sargento Petterson, Juiz Rogério e o Comandante Robson – todos parabenizando os soldados e destacando o empenho e profissionalismo de ambos. rnrnrnrnrnrnrnrnrnrnrnrnrnrnrnrnrnrn
Fonte: jrdiario